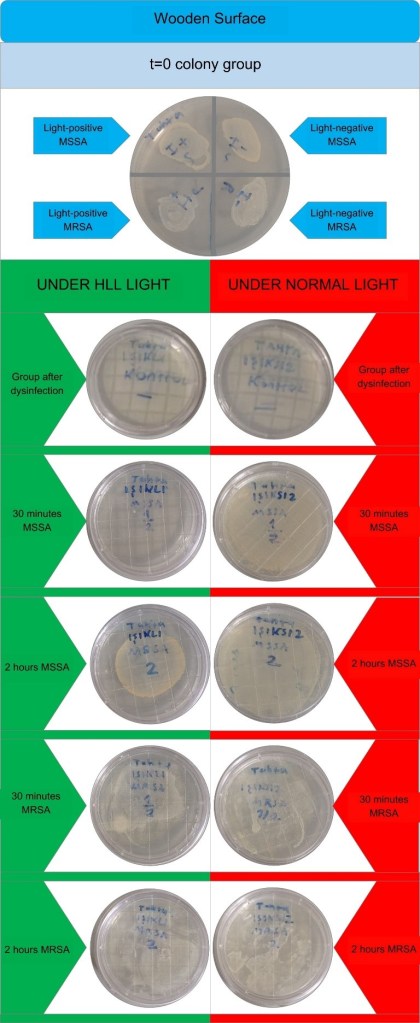
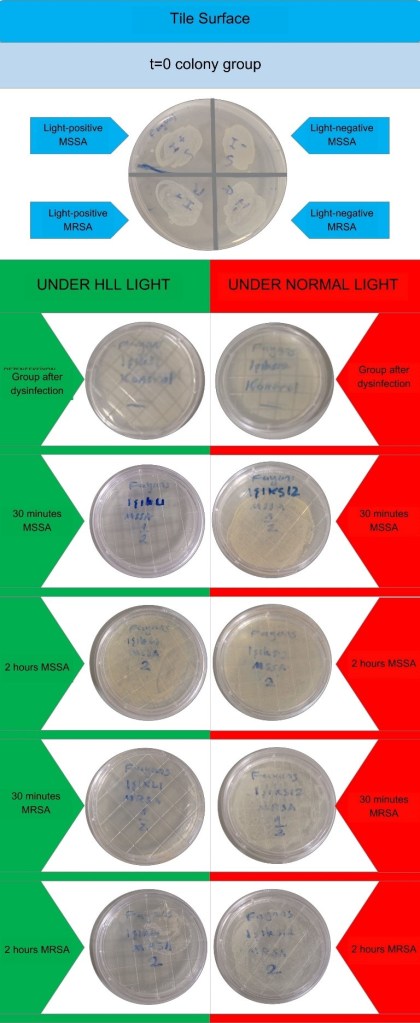

Ahmet Hakan Çelik1, Ahmet Tarik Yanık1
1 Microbiology Laboratory, Private Erdem Hospital, Istanbul, Türkiye.
Received: 10 August 2024
Revised: 19 August 2024
Accepted: 19 August 2024
Published: 26 August 2024
Corresponding author:
Ahmet Hakan Çelik.
Microbiology Laboratory, Private Erdem Hospital, Istanbul, Türkiye. ahcitalyahc@gmail.com
Cite as:
| Çelik AH, Yanık AT. MSSA and MRSA Photoinactivation with Hygienic LED Light. Acta Med Eur. 2024;6(4):16-20. doi: 10.5281/zenodo.13372152 |
ABSTRACT
doi: 10.5281/zenodo.13372152
| The aim of this study was to investigate the effect of HL on the growth of Methicillin-resistant Staphylococcus aureus (MRSA) and Methicillin-susceptible S. aureus (MSSA) isolates. In our study, wood and tiles were used as experimental surfaces, and a Sezber Technology brand (Istanbul, Turkey), 9W 1175 lumen hygienic LED bulb with White Daylight features and a standard White Daylight lamp were used as light sources. MRSA and MSSA type bacteria were prepared for use in surface spreading. Plastic cell spreaders and direct contact petri dishes were used in the inoculation of isolates. Two surfaces, one tile and one wood, were placed in two different rooms. Each different experimental surface was divided into two different areas of 10×10 cm using tape for the cultivation of MRSA and MSSA isolates. In one of the rooms, HLL was used as a light source, 60 cm above the experimental surfaces, and in the other room, a White Daylight lamp with standard ceiling height was used. After the experimental surfaces were cleaned with ethanol-based disinfectant, they were rinsed with 0.9% NaCl isotonic solution. After disinfection, Mueller-Hinton (MH) and Plate Count Agar (PCA) cultures were made for the negative control group from the experimental surfaces. For MSSA, no bacterial growth was observed in the HLL light group in the 30-minute groups, but the HLL unlighted group showed bacterial growth. Bacterial growth was observed in both 2nd hour groups, but the colony diameters were smaller in the HLL lighted group. Among the 30-minute petri dishes of the wooden surface MRSA groups, the HLL lighted group had less bacterial spread. Colony diameters were similar in both petri dishes in the 2-hour group. No bacterial growth was observed in the tile surface groups after disinfection. No bacterial growth was observed in the HLL lighted MSSA group after 30 minutes, while growth was observed in the HLL unlighted group. Bacterial growth was observed in both 2-hour MSSA groups, and colony diameters were similar. In the tile surface MRSA groups, no bacterial growth was observed in the HLL lighted group after 30 minutes, while growth was observed in the HLL unlighted group. Bacterial growth was observed in both 2-hour groups, but both bacterial spread and colony diameters were much less in the HLL light group than in the HLL-free group. This study revealed that HLL technology is effective in the context of continuous disinfection of the environment. HLL technology, which is effective in reducing the effectiveness of both MRSA and MSSA type bacteria in a short time such as 30 minutes, increases the hygiene level of the environment in which it is located. It seems possible that the use of HLL technology in home and hospital environments may reduce MRSA and MSSA-related diseases or deaths. Compared to other methods where chemicals are predominantly used, the fact that it is less harmful to health and less costly makes this technology more useful in economic terms. Continuous disinfection minimizes the risk of infection. |
Keywords:
MRSA, MSSA, Staphylococcus aureus, LED light, antimicrobial, hygienic.
INTRODUCTION
Hospital infections caused by the presence of bacteria in hospital environments are a serious health problem worldwide and cause the death of approximately 100,000 people each year. These infections can easily be transmitted through contact with surfaces containing bacteria or through contaminated air. One of the most effective methods for preventing such infections is regular disinfection. However, traditional disinfection methods require high human activity, intensive chemical use, and time-consuming processes. This creates an economic and operational burden for both hospitals and other living spaces (1-3).
Ultraviolet and blue light technologies in particular have been in use for a long time due to their effects on microorganisms. However, the negative effects of these types of light on other living things limit their areas of use. Hygienic LED Light (HLL) technology offers an innovative solution with light-based inactivation using only electrical energy. In addition to being financially efficient, HLL reduces the negative impacts on the environment by eliminating the use of chemicals and saves manpower. With these features, HLL stands out as a more sustainable and applicable alternative compared to traditional disinfection methods (2-4).
Hygienic LED Light technology can be used not only in hospital environments but also in home environments. In the home environment, HLL creates an effective defense mechanism against bacteria that can be carried by people or pets from outside. Light-based bacterial disinfection, which is currently successfully applied in hospitals around the world, is becoming more accessible thanks to HLL technology and offers the opportunity to be used in homes. In this way, an important step has been taken in terms of public health and the spread of infections can be significantly controlled (1-5).
The aim of this study was to investigate the effect of HL on the growth of Methicillin-resistant Staphylococcus aureus (MRSA) and Methicillin-susceptible S. aureus (MSSA) isolates.
METHODS
In our study, wood and tiles were used as experimental surfaces, and a Sezber Technology brand (Istanbul, Turkey), 9W 1175 lumen hygienic LED bulb with White Daylight features and a standard White Daylight lamp were used as light sources. MRSA and MSSA type bacteria were prepared for use in surface spreading. Plastic cell spreaders and direct contact petri dishes were used in the inoculation of isolates.
Two surfaces, one tile and one wood, were placed in two different rooms. Each different experimental surface was divided into two different areas of 10×10 cm using tape for the cultivation of MRSA and MSSA isolates. In one of the rooms, HLL was used as a light source, 60 cm above the experimental surfaces, and in the other room, a White Daylight lamp with standard ceiling height was used. After the experimental surfaces were cleaned with ethanol-based disinfectant, they were rinsed with 0.9% NaCl isotonic solution.
After disinfection, Mueller-Hinton (MH) and Plate Count Agar (PCA) cultures were made for the negative control group from the experimental surfaces. After the negative control group was taken, 0.5 McFarland 100 µl MRSA and 0.5 McFarland 100 µl MSSA bacterial solutions were spread on one of the experimental surfaces, each of which was divided into two different areas. After spreading, MH and PCA cultures were made for the positive control group from each area.
After obtaining the positive control groups, MRSA and MSSA groups were placed under two different light sources, and MH and PCA cultures were made from each area at the 30th minute and 2nd hour intervals. Each sample cultivated before the second hour was kept in the refrigerator, and all samples were placed in the incubator at the end of the second hour. The results were read after the samples were kept in the incubator for 24 hours. Two factors were observed when reading the results: i) the spread of bacterial growth, representing the number of colonies, ii) colony diameters, indicating colony proliferation.
RESULTS
After disinfection, no bacterial growth was observed in the HLL light and unlighted groups of the wooden surface group. For MSSA, no bacterial growth was observed in the HLL light group in the 30-minute groups, but the HLL unlighted group showed bacterial growth. Bacterial growth was observed in both 2nd hour groups, but the colony diameters were smaller in the HLL lighted group. Among the 30-minute petri dishes of the wooden surface MRSA groups, the HLL lighted group had less bacterial spread. Colony diameters were similar in both petri dishes in the 2-hour group (Figure 1).
No bacterial growth was observed in the tile surface groups after disinfection. No bacterial growth was observed in the HLL lighted MSSA group after 30 minutes, while growth was observed in the HLL unlighted group. Bacterial growth was observed in both 2-hour MSSA groups, and colony diameters were similar. In the tile surface MRSA groups, no bacterial growth was observed in the HLL lighted group after 30 minutes, while growth was observed in the HLL unlighted group. Bacterial growth was observed in both 2-hour groups, but both bacterial spread and colony diameters were much less in the HLL light group than in the HLL-free group (Figure 2).
When the samples kept in the incubator for 24 hours were examined, it was observed that the colony diameters in the experimental groups under hygienic light were smaller and the spread area was narrower. It was determined that the spread width in the 32-square-unit Plate Count Agar experimental groups decreased by an average of 15 square units for MSSA and 11.5 square units for MRSA. The Mueller-Hinton Agar experimental groups revealed that the bacterial spread decreased from an uncountable number of colonies to 100-250 colonies.
Figure 1. Comparison of the cultures on wooden surface.
HLL: Hygienic LED light, MSSA: Methicillin-susceptible Staphylococcus aureus, MRSA: Methicillin-resistant S. aureus.
Figure 2. Comparison of the cultures on tile surface.
HLL: Hygienic LED light, MSSA: Methicillin-susceptible Staphylococcus aureus, MRSA: Methicillin-resistant S. aureus.
DISCUSSION
Disinfection of microorganisms from surfaces has been done for a long time with light technology. However, studies on light types that will not harm other living things and can be used in environments such as homes are ongoing (4-8). In our study, it was shown that hygienic LED light is effective on staphylococci. Ergün et al. (5) reported that all isolates showed growth inhibition after 15 minutes of exposure to hygienic LED in their study with S. aureus, Psueudomonas aeruginosa and Candida albicans isolates. Fabric, glass, metal and plastic surfaces were used in the study and it was reported that hygienic LED light inhibited microorganism growth on all surfaces. Dos Anjos et al. (6) worked on Klebsiella species with visible light and showed the antimicrobial effect of light. Again, dos Anjos et al. (7) In another study, it was determined that antimicrobial blue light was effective on extended spectrum beta-lactamase in Escherichia coli isolates. Miyata et al. (8) reported that blue LED technology had an antimicrobial effect on some microorganisms that are common infectious agents in dentistry. Trujillo-Casarreal et al. (9) showed that microwave-assisted visible LED light had an antimicrobial effect on S. aureus and E. oli. Ribeiro et al. (10) found that photodynamic therapy induced by LED light was effective on MRSA and vancomycin intermediate-susceptible S. aureus (VISA) strains. Zhang et al. (11) reported that wireless blue light technology was effective on biofilms in root canal treatment. Soares et al. (12) also prevented biofilm formation in orthodontic treatment with blue light technology. Hirose et al. (13) reported that blue light was effective on Song et al. (14) inhibited Porphyromonas growth with light technology. Petrini et al. (15) obtained antimicrobial effect against P. aeruginosa with LED light. They showed antimicrobial effect on microorganisms that cause dental caries. In our study, no bacterial growth was observed in the HLL light group in the 30-minute groups for MSSA, but bacterial growth was observed in the HLL-free group. Bacterial growth was observed in both of the 2nd hour groups, but colony diameters were smaller in the HLL-light group. In the study, less bacterial spread was observed in the HLL-light group among the 30-minute petri dishes of the wooden surface MRSA groups. Colony diameters were similar in both petri dishes in the 2-hour group. No bacterial growth was observed in the tile surface groups after disinfection. No bacterial growth was observed in the HLL-light MSSA group after 30 minutes, while growth was observed in the HLL-free group. Bacterial growth was observed in both 2-hour MSSA groups and colony diameters were found to be similar. In our study, in the tile surface MRSA groups, no bacterial growth was observed in the HLL light group after 30 minutes, while growth was detected in the HLL unlit group. Bacterial growth was observed in both 2-hour groups, but in the HLL light group, both bacterial spread and colony diameters were much less than in the HLL unlit group. When the samples kept in the incubator for 24 hours were examined, it was observed that the colony diameters in the experimental groups under hygienic light were smaller and the spread area narrowed. It was determined that the spread width in the 32 square unit Plate Count Agar experimental groups decreased by an average of 15 square units for MSSA and 11.5 square units for MRSA. Mueller-Hinton Agar experimental groups revealed that the bacterial spread decreased from an uncountable number of colonies to 100-250 colonies. All these findings show that S. aureus isolates exposed to hygienic LED light technology are affected by light regardless of the surface being studied, that this LED light has an inhibitory effect on staphylococcal growth, and that the duration of exposure to light directly affects the growth inhibitory feature.
There were some limitations in our study. The experiments in the study were not tested on different types and a large number of isolates, which may have increased the possibility of error in the analyses. However, the fact that the experiments were conducted on different surfaces and a large number of cultures and that the controlled work was carried out with normal light may have minimized this negative effect of the analyses.
This study revealed that HLL technology is effective in the context of continuous disinfection of the environment. HLL technology, which is effective in reducing the effectiveness of both MRSA and MSSA type bacteria in a short time such as 30 minutes, increases the hygiene level of the environment in which it is located. It seems possible that the use of HLL technology in home and hospital environments may reduce MRSA and MSSA-related diseases or deaths. Compared to other methods where chemicals are predominantly used, the fact that it is less harmful to health and less costly makes this technology more useful in economic terms. Continuous disinfection minimizes the risk of infection.
Acknowledgement
We would like to thank Erdem Hospital managers and laboratory staff for their great contributions to our work.
CC BY Licence
This is an open access article under the CC BY license (http://creativecommons.org/licenses/by/4.0/)
REFERENCES
- Schöbel H, Diem G, Kiechl J, et al. Antimicrobial efficacy and inactivation kinetics of a novel LED-based UV-irradiation technology. J Hosp Infect. 2023;135:11-17. doi: 10.1016/j.jhin.2022.12.023.
- Niu L, Wu Z, Yang L, Wang Y, Xiang Q, Bai Y. Antimicrobial Effect of UVC Light-Emitting Diodes against Saccharomyces cerevisiae and Their Application in Orange Juice Decontamination. J Food Prot. 2021;84(1):139-146. doi: 10.4315/JFP-20-200.
- Jana S, Heaven MR, Dahiya N, et al. Antimicrobial 405 nm violet-blue light treatment of ex vivo human platelets leads to mitochondrial metabolic reprogramming and potential alteration of Phospho-proteome. J Photochem Photobiol B. 2023;241:112672. doi: 10.1016/j.jphotobiol.2023.112672.
- Moradi M, Fazlyab M, Pourhajibagher M, Chiniforush N. Antimicrobial action of photodynamic therapy on Enterococcus faecalis biofilm using curing light, curcumin and riboflavin. Aust Endod J. 2022;48(2):274-282. doi: 10.1111/aej.12565.
- Ergün M, Caner M, Peker SA. Investigation Of Daylight Hygiene Technology ın Prevention of Healthcare Related Infections. Uluslararası Sterilizasyon Cerrahi Enfeksiyon Hemşireliği Dergisi. 2022;2(2):51-63. doi: 10.5281/zenodo.7135364
- Dos Anjos C, Sellera FP, Ribeiro MS, et al. Antimicrobial blue light and photodynamic therapy inhibit clinically relevant β-lactamases with extended-spectrum (ESBL) and carbapenemase activity. Photodiagnosis Photodyn Ther. 2020;32:102086. doi: 10.1016/j.pdpdt.2020.102086.
- Dos Anjos C, Sabino CP, Sellera FP, Esposito F, Pogliani FC, Lincopan N. Hypervirulent and hypermucoviscous strains of Klebsiella pneumoniae challenged by antimicrobial strategies using visible light. Int J Antimicrob Agents. 2020;56(1):106025. doi: 10.1016/j.ijantimicag.2020.106025.
- Miyata S, Miyaji H, Kawasaki H, Yamamoto M, Nishida E, Takita H, Akasaka T, Ushijima N, Iwanaga T, Sugaya T, et al. Antimicrobial photodynamic activity and cytocompatibility of Au25(Capt)18 clusters photoexcited by blue LED light irradiation. Int J Nanomedicine. 2017;12:2703-2716. doi: 10.2147/IJN.S131602.
- Trujillo-Casarreal JD, Morales-Jiménez JI, Núñez-Luna BP, Barrera-Rendón EM, Rodríguez González V. Unraveling the antimicrobial activity of CuS functionalized titanates under visible LED light irradiation. Chemosphere. 2024;359:142317. doi: 10.1016/j.chemosphere.2024.142317.
- Ribeiro IS, Muniz IPR, Galantini MPL, et al. Characterization of Brazilian green propolis as a photosensitizer for LED light-induced antimicrobial photodynamic therapy (aPDT) against methicillin-resistant Staphylococcus aureus (MRSA) and Vancomycin-intermediate Staphylococcus aureus (VISA). Photochem Photobiol Sci. 2023;22(12):2877-2890. doi: 10.1007/s43630-023-00495-1.
- Zhang L, Li Y, Zhang Q, et al. Antimicrobial Activity of an Implantable Wireless Blue Light-Emitting Diode Against Root Canal Biofilm In Vitro. Photobiomodul Photomed Laser Surg. 2020;38(11):694-702. doi: 10.1089/photob.2020.4821.
- Soares LGP, de Almeida CG, Crugeira PJL, et al. Photodynamic antimicrobial therapy (A-PDT) using 1,9-Dimethyl-Methylene Blue zinc chloride double salt – DMMB and λ640 ± 5ηm LED light in patients undertaking orthodontic treatment. Photodiagnosis Photodyn Ther. 2023;42:103503. doi: 10.1016/j.pdpdt.2023.103503.
- Hirose M, Yoshida Y, Horii K, Hasegawa Y, Shibuya Y. Efficacy of antimicrobial photodynamic therapy with Rose Bengal and blue light against cariogenic bacteria. Arch Oral Biol. 2021;122:105024. doi: 10.1016/j.archoralbio.2020.105024.
- Song Y, Lin J, Zhang Z, Xu B, Bi L. Antimicrobial effect of photodynamic therapy using sinoporphyrin sodium and 390-400 nm light-emitting diode on Porphyromonas gingivalis in vitro. Lasers Med Sci. 2021;36(1):153-164. doi: 10.1007/s10103-020-03067-2.
- Petrini M, Trentini P, Tripodi D, Spoto G, D’Ercole S. In vitro antimicrobial activity of LED irradiation on Pseudomonas aeruginosa. J Photochem Photobiol B. 2017;168:25-29. doi: 10.1016/j.jphotobiol.2017.01.020.
